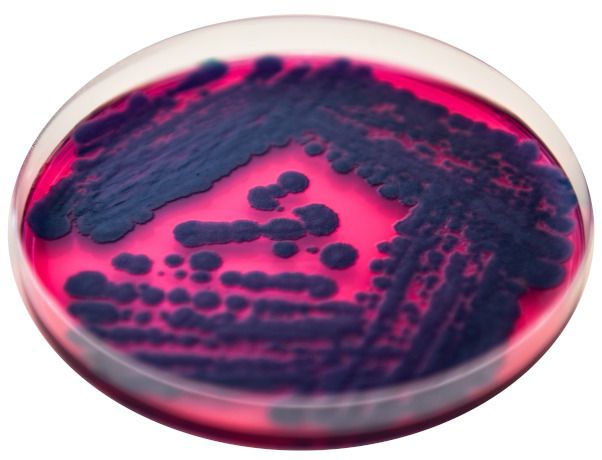
Bacillus mycoides

Talirapsi täiendväetamine mullaherbitsiidiga
Muld on põllumajandustootja peamine töövahend, mistõttu on oluline hoida see terve ning produktiivsena. Toetades mulla mikrofloorat, loome mulla omaduste paranemisega taimedele soodsama kasvukeskkonna.
Mullaherbitsiidi paagisegusse (loe lähemalt) sobivad ideaalselt mitmed mulla omadusi parandavad ning taimede kasvu ja arengut soodustavad tooted. Need tagavad taimestiku ühtlasema tärkamise, hästi arenenud juurestiku ja kiirendavad taimede algarengut. Eelnevate aastate sügised on selgelt näidanud, et taimede algarengut on vaja omalt poolt igati toetada. Kui taim sügisel ühtlaselt tärkab ja sügavale ulatuva juurekava kasvatab, siis on talvitumine ja kevad-suviste heitlike ilmastikuoludega toimetulek lihtsam.
Selle kombinatsiooni eeliseks on taimestiku ühtlasem tärkamine, hästi arenenud juurestik ning taimede kiire algareng. Humistaris sisalduvad humiinhapped muudavad mullas olevad fosfori lahustumatud ühendid taimedele paremini kättesaadavaks. Humistar on huumusainete poolest 20 korda kontsentreeritum kui orgaaniline väetis ning 300 korda kontsentreeritum kui keskmine põllumuld. Soovitame segusse Ruter AA-ga, kuid oluline on jälgida, et taimik ei kataks pritsimise hetkel kogu mullapinda ega takistaks Humistari jõudmist mullale. Vabu aminohappeid ja toiteelemente sisaldav Ruter AA soodustab narmasjuurte arengut ning parandab toitainete kättesaadavust. Paraneb taimede vastupidavus liigniiskusest või kuivusest tulenevale stressile.
BioSpektrum sisaldab kasulikke mikroorganisme. Toote kasutamisel paraneb mulla bioloogiline aktiivsus ja struktuur, makro- ja mikroelementide omastatavus, taimede stressitaluvus ja haiguskindlus. Mikroorganismid soodustavad ka juurestiku kasvu. Oma elutegevuse käigus eritavad mikroorganismid mulda antibiootilisi aineid, mis aitavad eemale hoida mulla kaudu levivaid patogeene. Lisaks sisaldab BioSpektrum mükoriisaseeni, mis toodavad glükoproteiin-globuliin. See ühendab väikesed mullaosakesed suuremateks agregaatideks, parandades seeläbi mullastruktuuri. Toote mõju taimedele ja mullale on pikaajaline. Kuna mikroorganismid moodustavad spoore, mis ei ole tundlikud ebasoodsate keskkonnatingimuste suhtes, siis jätkub mikroorganismide positiivne mõju ka kevadel.
Mõned näited tootes sisalduvate bakterite funktsioonide kohta:
Bacillus megaterium – fosfaate lahustav bakter, kes eritab happelisi fosfataase ja fütaase, mis aitavad viia fosfaadi lahustumatu vormi juurte kaudu omastatavasse vormi.
Bacillus mucilaginosus – bakter, kes vabastab kaaliumi mineraalsetest vormidest.
Bacillus mycoides – bakter, kes lahustab ja vabastab ränimineraalidest ränidioksiidi.
 Bacillus megaterium
Bacillus megaterium Bacillus mycoides
Bacillus mycoidesBacilluse perekonna baktereid kasutatakse erinevates bioloogilistes toodetes kõige sagedamini. Selle bakterirühma peamisteks eelisteks on nende lihtne kasvatamine ja võime moodustada endospoore – keskkonnamõjudele ääretult vastupidavaid struktuure. Tänu sellele on tooted tehnoloogilise töötlemise suhtes vähem nõudlikud.
Põldudel, kus on palju taimejäänuseid ja viljeletakse minimeeritud harimist, soovitame lagunemisprotsessi kiirendamiseks mikroorganismide poolt bioloogiliselt sünteesitud ensüüme ning mikroorganisme, kes neid ensüüme toodavad. BioSplito on bioloogiline toode, mida soovitame kasutada kohe pärast eelkultuuri koristamist eraldi, koos glüfosaadiga või talirapsi mullaherbitsiidiga. Tänu põhu paremale lagunemisele paraneb mulla struktuur ning füüsikalised ja bioloogilised omadused. Muld rikastub taimedele kättesaadavate toiteelementidega ning väheneb toksiinide ja hallituse tekke risk.
Kasutamissoovitused
BioSpektrum pritsitakse mullapinnale enne või pärast külvide tärkamist (segus herbitsiididega) kulunormiga 0,25 kg/ha. Kui mingil põhjusel jäi pärast saagi koristamist põllul BioSplito kasutamata, siis mullaherbitsiidi paagisegus oleks seda viimane hetk teha segus BioSpektrumiga. Sellisel juhul on pritsimisel kulunormid: BioSplito kulunormiga 0,75 kg/ha + BioSpektrum kulunormiga 0,25 kg/ha.
Biopreparaatide mõju taimedele ja mullale on pikaajaline. Toetades mulda ja seal elavaid kasulikke mikroorganisme, on võimalik koristada kõrgem ja kvaliteetsem saak ning tagada taimedele parem vastupidavus ebasoodsatele kasvutingimustele ning haiguste ja kahjurite rünnakule.



